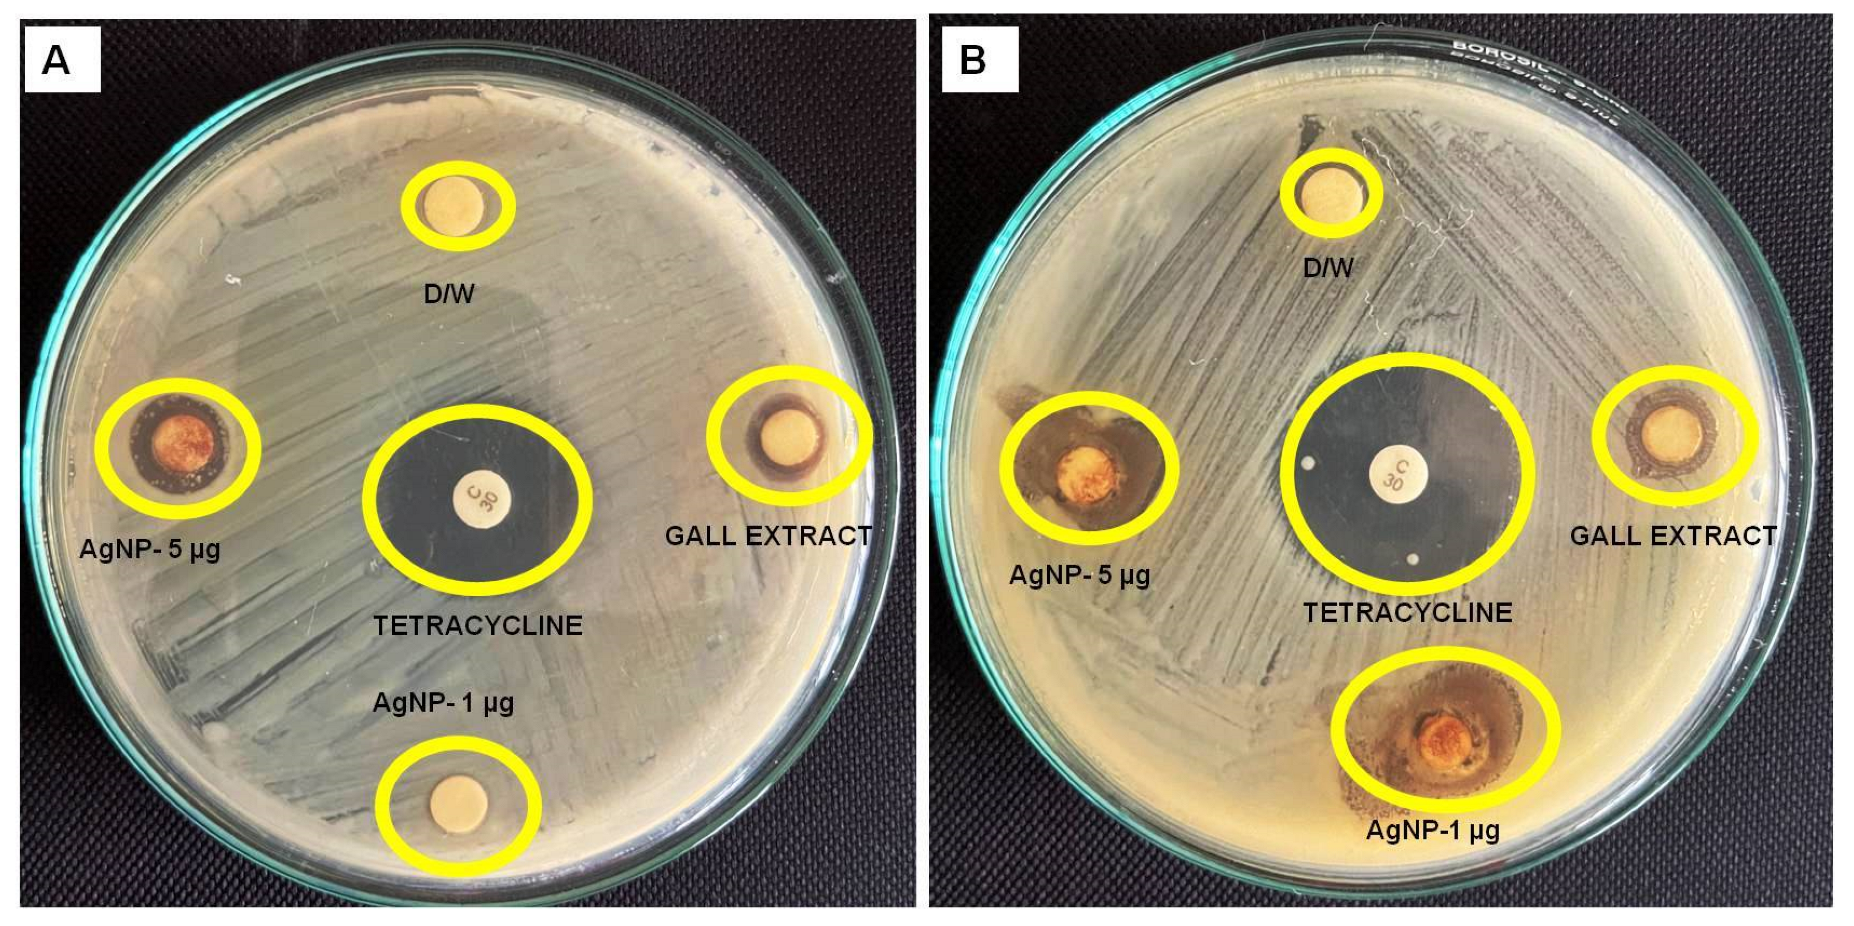
Pharmaceutics 16 01025 g009

From Ficus recemosa Leaf Galls to Therapeutic Silver Nanoparticles: Antibacterial and Anticancer Applications
Abstract
1. Introduction
2. Methodology
2.1. Collection of Plant Material
2.2. Synthesis of Silver Nanoparticles
2.3. Nanoparticle Characterization
2.3.1. UV-Vis Spectroscopy
2.3.2. Fourier-Transform Infrared Spectroscopy (FTIR)
2.3.3. HR-TEM Analysis
2.3.4. Zeta Potential Analysis
2.3.5. Dynamic Light Scattering (DLS) Size Analysis
2.3.6. LC-MS Q TOF Analysis of Gall Extract
2.4. Antibacterial Activity of AgNPs
2.5. Anticancer Assay
2.6. Environmental Toxicity Studies
3. Results and Discussion
3.1. UV-VIS Spectral Analysis
3.2. IR Spectral Analysis
3.3. TEM Analysis Data
3.4. DLS Analysis of AgNPs
3.5. Zeta Potential
3.6. LC-MS Q-TOF Analysis of Ficus racemosa Gall Extract
- (a)
- Alkaloids
- (b)
- Flavonoids
- (c)
- Phenolic Compounds
- (d)
- Terpenoids
- (e)
- Glycosides
- (f)
- Fatty Acids and Derivatives
- (g)
- Other Compounds
3.7. Antibacterial Activity of AgNPS
3.8. Anticancer Activity
3.9. Chromosomal Aberration Assay
4. Conclusions
Author Contributions
Funding
Institutional Review Board Statement
Informed Consent Statement
Data Availability Statement
Acknowledgments
Conflicts of Interest
References
- Hasan, S. A Review on Nanoparticles: Their Synthesis and Types. Res. J. Recent Sci. 2015, 4, 1–3. [Google Scholar]
- Kharissova, O.V.; Dias, H.V.R.; Kharisov, B.I.; Pérez, B.O.; Pérez, V.M.J. The Greener Synthesis of Nanoparticles. Trends Biotechnol. 2013, 31, 240–248. [Google Scholar] [CrossRef] [PubMed]
- Modena, M.M.; Rühle, B.; Burg, T.P.; Wuttke, S. Nanoparticle Characterization: What to Measure? Adv. Mater. 2019, 31, 1901556. [Google Scholar] [CrossRef]
- Bhosale, M.A.; Bhanage, B.M. Silver Nanoparticles: Synthesis, Characterization and Their Application as a Sustainable Catalyst for Organic Transformations. Curr. Org. Chem. 2015, 19, 708–727. [Google Scholar] [CrossRef]
- Ajaykumar, A.P.; Sabira, O.; Sebastian, M.; Varma, S.R.; Roy, K.B.; Binitha, V.S.; Rasheed, V.A.; Jayaraj, K.N.; Vignesh, A.R. A Novel Approach for the Biosynthesis of Silver Nanoparticles Using the Defensive Gland Extracts of the Beetle, Luprops tristis Fabricius. Sci. Rep. 2023, 13, 10186. [Google Scholar] [CrossRef] [PubMed]
- Wong, K.K.Y.; Cheung, S.O.F.; Huang, L.; Niu, J.; Tao, C.; Ho, C.-M.; Che, C.-M.; Tam, P.K.H. Further Evidence of the Anti-Inflammatory Effects of Silver Nanoparticles. ChemMedChem 2009, 4, 1129–1135. [Google Scholar] [CrossRef] [PubMed]
- Zhang, X.-F.; Liu, Z.-G.; Shen, W.; Gurunathan, S. Silver Nanoparticles: Synthesis, Characterization, Properties, Applications, and Therapeutic Approaches. Int. J. Mol. Sci. 2016, 17, 1534. [Google Scholar] [CrossRef] [PubMed]
- Ajaykumar, A.P.; Mathew, A.; Chandni, A.P.; Varma, S.R.; Jayaraj, K.N.; Sabira, O.; Rasheed, V.A.; Binitha, V.S.; Swaminathan, T.R.; Basheer, V.S.; et al. Green Synthesis of Silver Nanoparticles Using the Leaf Extract of the Medicinal Plant, Uvaria Narum and Its Antibacterial, Antiangiogenic, Anticancer and Catalytic Properties. Antibiotics 2023, 12, 564. [Google Scholar] [CrossRef] [PubMed]
- Ajaykumar, A.P.; Sabira, O.; Binitha, V.S.; Varma, S.R.; Mathew, A.; Jayaraj, K.N.; Janish, P.A.; Zeena, K.V.; Sheena, P.; Venugopal, V.; et al. Bio-Fabricated Silver Nanoparticles from the Leaf Extract of the Poisonous Plant, Holigarna Arnottiana: Assessment of Antimicrobial, Antimitotic, Anticancer, and Radical-Scavenging Properties. Pharmaceutics 2023, 15, 2468. [Google Scholar] [CrossRef]
- Sabira, O.; Anthyalam Parambil, A. Bio-Synthesis of Copper Oxide Nanoparticles Using Beetle Defensive Gland Extract: Exploring Diverse Applications. Int. J. Nano Dimens. 2024, 659, e844f1d071. [Google Scholar] [CrossRef]
- Keat, C.L.; Aziz, A.; Eid, A.M.; Elmarzugi, N.A. Biosynthesis of Nanoparticles and Silver Nanoparticles. Bioresour. Bioprocess. 2015, 2, 47. [Google Scholar] [CrossRef]
- Mani, M.S. Ecology of Plant Galls; Springer: Dordrecht, The Netherlands, 2013; ISBN 978-94-017-6230-4. [Google Scholar]
- Harris, M.O.; Pitzschke, A. Plants Make Galls to Accommodate Foreigners: Some Are Friends, Most Are Foes. New Phytol. 2020, 225, 1852–1872. [Google Scholar] [CrossRef] [PubMed]
- Patil, M.P.; Rokade, A.A.; Ngabire, D.; Kim, G.-D. Green Synthesis of Silver Nanoparticles Using Water Extract from Galls of Rhus Chinensis and Its Antibacterial Activity. J. Clust. Sci. 2016, 27, 1737–1750. [Google Scholar] [CrossRef]
- Khatamifar, M.; Fatemi, S.J.; Torkzadeh-Mahani, M.; Mohammadi, M.; Hassanshahian, M. Green and Eco-Friendly Synthesis of Silver Nanoparticles by Quercus infectoria Galls Extract: Thermal Behavior, Antibacterial, Antioxidant and Anticancer Properties. Part. Sci. Technol. 2022, 40, 281–289. [Google Scholar] [CrossRef]
- Banc, R.; Rusu, M.E.; Filip, L.; Popa, D.-S. Phytochemical Profiling and Biological Activities of Quercus Sp. Galls (Oak Galls): A Systematic Review of Studies Published in the Last 5 Years. Plants 2023, 12, 3873. [Google Scholar] [CrossRef] [PubMed]
- Mustapha, T.; Misni, N.; Ithnin, N.R.; Daskum, A.M.; Unyah, N.Z. A Review on Plants and Microorganisms Mediated Synthesis of Silver Nanoparticles, Role of Plants Metabolites and Applications. Int. J. Environ. Res. Public Health 2022, 19, 674. [Google Scholar] [CrossRef] [PubMed]
- Ahmed, F.; Urooj, A. Traditional Uses, Medicinal Properties, and Phytopharmacology of Ficus racemosa: A Review. Pharm. Biol. 2010, 48, 672–681. [Google Scholar] [CrossRef]
- Bhalerao, S.; Verma, D.; Teli, N.; Didwana, V.; Thakur, S. Ficus racemosa Linn.: A Comprehensive Review. J. Appl. Chem. 2014, 3, 1423–1431. [Google Scholar]
- Deep, P.; Singh, A.K. Pharmacological Potentials of Ficus racemosa—A Review. Int. J. Pharm. Sci. Rev. Res. 2013, 22, 29–34. [Google Scholar]
- Yadav, R.K.; Nandy, B.C.; Maity, S.; Sarkar, S.; Saha, S. Phytochemistry, Pharmacology, Toxicology, and Clinical Trial of Ficus racemosa. Pharmacogn. Rev. 2015, 9, 73–80. [Google Scholar] [CrossRef]
- Subba Rao, Y.; Kotakadi, V.S.; Prasad, T.N.V.K.V.; Reddy, A.V.; Sai Gopal, D.V.R. Green Synthesis and Spectral Characterization of Silver Nanoparticles from Lakshmi Tulasi (Ocimum sanctum) Leaf Extract. Spectrochim. Acta Part A Mol. Biomol. Spectrosc. 2013, 103, 156–159. [Google Scholar] [CrossRef] [PubMed]
- Shaik, M.R.; Khan, M.; Kuniyil, M.; Al-Warthan, A.; Alkhathlan, H.Z.; Siddiqui, M.R.H.; Shaik, J.P.; Ahamed, A.; Mahmood, A.; Khan, M.; et al. Plant-Extract-Assisted Green Synthesis of Silver Nanoparticles Using Origanum vulgare L. Extract and Their Microbicidal Activities. Sustainability 2018, 10, 913. [Google Scholar] [CrossRef]
- Mathew, A.; Analiparambil Ravindran, R.; Vazhanthodi, A.R.; Valiyaparmbil Sivadasan, B.; Ovungal, S.; Madathilpadi Subrahmanian, S.; Chittadimangalath, P.; Anthyalam Parambil, A. Microwave-Assisted Greener Synthesis of Silver Nanoparticles Using Entada Rheedii Leaf Extract and Investigation of Its Anticancer and Antimicrobial Properties. Int. J. Nano Dimens. 2022, 13, 329–334. [Google Scholar]
- Perveen, R.; Shujaat, S.; Naz, M.; Qureshi, M.Z.; Nawaz, S.; Shahzad, K.; Ikram, M. Green Synthesis of Antimicrobial Silver Nanoparticles with Brassicaceae Seeds. Mater. Res. Express 2021, 8, 055007. [Google Scholar] [CrossRef]
- Zayed, M.F.; Eisa, W.H.; Shabaka, A.A. Malva parviflora Extract Assisted Green Synthesis of Silver Nanoparticles. Spectrochim. Acta Part A Mol. Biomol. Spectrosc. 2012, 98, 423–428. [Google Scholar] [CrossRef] [PubMed]
- Jain, S.; Mehata, M.S. Medicinal Plant Leaf Extract and Pure Flavonoid Mediated Green Synthesis of Silver Nanoparticles and Their Enhanced Antibacterial Property. Sci. Rep. 2017, 7, 15867. [Google Scholar] [CrossRef]
- Nandiyanto, A.; Ragadhita, R.; Fiandini, M.; Ijost, I. Interpretation of Fourier Transform Infrared Spectra (FTIR): A Practical Approach in the Polymer/Plastic Thermal Decomposition. Indones. J. Sci. Technol. 2023, 8, 113–126. [Google Scholar] [CrossRef]
- Oh, S.Y.; Yoo, D.I.; Shin, Y.; Seo, G. FTIR Analysis of Cellulose Treated with Sodium Hydroxide and Carbon Dioxide. Carbohydr. Res. 2005, 340, 417–428. [Google Scholar] [CrossRef]
- Das, K.; Kendall, C.; Isabelle, M.; Fowler, C.; Christie-Brown, J.; Stone, N. FTIR of Touch Imprint Cytology: A Novel Tissue Diagnostic Technique. J. Photochem. Photobiol. B Biol. 2008, 92, 160–164. [Google Scholar] [CrossRef]
- Zenobi, M.C.; Luengo, C.V.; Avena, M.J.; Rueda, E.H. An ATR-FTIR Study of Different Phosphonic Acids in Aqueous Solution. Spectrochim. Acta Part A Mol. Biomol. Spectrosc. 2008, 70, 270–276. [Google Scholar] [CrossRef]
- Yuan, Y.; Teja, A.S. Quantification of Specific Interactions between CO2 and the Carbonyl Group in Polymers via ATR-FTIR Measurements. J. Supercrit. Fluids 2011, 56, 208–212. [Google Scholar] [CrossRef]
- Bala, K.; Barmanray, A. Functional Group Analysis of Lyophilized Pulp and Seed Powder of Phalsa (Grewia asiatica). J. Pharmacogn. Phytochem. 2019, 8, 873–878. [Google Scholar]
- Zhao, Z.; Yang, Z.; Hu, Y.; Li, J.; Fan, X. Multiple Functionalization of Multi-Walled Carbon Nanotubes with Carboxyl and Amino Groups. Appl. Surf. Sci. 2013, 276, 476–481. [Google Scholar] [CrossRef]
- Daffalla, S.; Mukhtar, H.; Shaharun, M. Characterization of Adsorbent Developed from Rice Husk: Effect of Surface Functional Group on Phenol Adsorption. J. Appl. Sci. 2010, 10, 1060–1067. [Google Scholar] [CrossRef]
- Al ahmad, A.; Al-Zereini, W.A.; Hijazin, T.J.; Al-Madanat, O.Y.; Alghoraibi, I.; Al-Qaralleh, O.; Al-Qaraleh, S.; Feldhoff, A.; Walter, J.G.; Scheper, T. Green synthesis of silver nanoparticles using Hypericum perforatum L. aqueous extract with the evaluation of its antibacterial activity against clinical and food pathogens. Pharmaceutics 2022, 14, 1104. [Google Scholar] [CrossRef] [PubMed]
- Roy, K.; Sarkar, C.K.; Ghosh, C.K. Photocatalytic Activity of Biogenic Silver Nanoparticles Synthesized Using Yeast (Saccharomyces cerevisiae) Extract. Appl. Nanosci. 2015, 5, 953–959. [Google Scholar] [CrossRef]
- Kudle, K.; Donda, M.; Merugu, R.; Prashanthi, Y.; Rudra, M. Microwave Assisted Green Synthesis of Silver Nanoparticles Using Stigmaphyllon Littorale Leaves Their Characterization and Anti-Microbial Activity. Int. J. Nanomater. Biostructures 2013, 3, 13–16. [Google Scholar]
- Bindhu, M.R.; Umadevi, M. Synthesis of Monodispersed Silver Nanoparticles Using Hibiscus cannabinus Leaf Extract and Its Antimicrobial Activity. Spectrochim. Acta Part A Mol. Biomol. Spectrosc. 2013, 101, 184–190. [Google Scholar] [CrossRef] [PubMed]
- Roopan, S.M.; Rohit; Madhumitha, G.; Rahuman, A.A.; Kamaraj, C.; Bharathi, A.; Surendra, T.V. Low-Cost and Eco-Friendly Phyto-Synthesis of Silver Nanoparticles Using Cocos nucifera Coir Extract and Its Larvicidal Activity. Ind. Crops Prod. 2013, 43, 631–635. [Google Scholar] [CrossRef]
- Singhal, G.; Bhavesh, R.; Kasariya, K.; Sharma, A.R.; Singh, R.P. Biosynthesis of Silver Nanoparticles Using Ocimum sanctum (Tulsi) Leaf Extract and Screening Its Antimicrobial Activity. J. Nanopart Res. 2011, 13, 2981–2988. [Google Scholar] [CrossRef]
- Mason, C.; Vivekanandhan, S.; Misra, M.; Mohanty, A.K. Switchgrass (Panicum virgatum) Extract Mediated Green Synthesis of Silver Nanoparticles. WJNSE 2012, 02, 47–52. [Google Scholar] [CrossRef]
- Anandalakshmi, K.; Venugobal, J.; Ramasamy, V. Characterization of Silver Nanoparticles by Green Synthesis Method Using Pedalium Murex Leaf Extract and Their Antibacterial Activity. Appl. Nanosci. 2016, 6, 399–408. [Google Scholar] [CrossRef]
- Ahmed, S.; Saifullah; Ahmad, M.; Swami, B.L.; Ikram, S. Green Synthesis of Silver Nanoparticles Using Azadirachta indica Aqueous Leaf Extract. J. Radiat. Res. Appl. Sci. 2016, 9, 1–7. [Google Scholar] [CrossRef]
- Shameli, K.; Ahmad, M.B.; Shabanzadeh, P.; Jaffar Al-Mulla, E.A.; Zamanian, A.; Abdollahi, Y.; Jazayeri, S.D.; Eili, M.; Jalilian, F.A.; Haroun, R.Z. Effect of Curcuma Longa Tuber Powder Extract on Size of Silver Nanoparticles Prepared by Green Method. Res. Chem. Intermed. 2014, 40, 1313–1325. [Google Scholar] [CrossRef]
- Carson, L.; Bandara, S.; Joseph, M.; Green, T.; Grady, T.; Osuji, G.; Weerasooriya, A.; Ampim, P.; Woldesenbet, S. Green Synthesis of Silver Nanoparticles with Antimicrobial Properties Using Phyla Dulcis Plant Extract. Foodborne Pathog. Dis. 2020, 17, 504–511. [Google Scholar] [CrossRef] [PubMed]
- Paosen, S.; Saising, J.; Wira Septama, A.; Piyawan Voravuthikunchai, S. Green Synthesis of Silver Nanoparticles Using Plants from Myrtaceae Family and Characterization of Their Antibacterial Activity. Mater. Lett. 2017, 209, 201–206. [Google Scholar] [CrossRef]
- Raj, S.; Chand Mali, S.; Trivedi, R. Green Synthesis and Characterization of Silver Nanoparticles Using Enicostemma axillare (Lam.) Leaf Extract. Biochem. Biophys. Res. Commun. 2018, 503, 2814–2819. [Google Scholar] [CrossRef] [PubMed]
- El Mannoubi, I.; Barrek, S.; Skanji, T.; Zarrouk, H. Antioxidant Activities and HPLC/UV/MS Characterization of Flavonoid Extracts from Opuntia ficus indica Seeds and Peels. Acta Hortic. 2010, 853, 189–198. [Google Scholar] [CrossRef]
- Elish, S.E.A.A.; Temraz, A.; Hassan Baky, M. Phytochemical Diversity of Genus Ficus: A Mini Review. ERU Res. J. 2023, 2, 502–524. [Google Scholar] [CrossRef]
- Lia, S.; Mohiuddin, A.K. Phytochemical Screening & Biological Investigations of Ficus racemosa. Open Access J. Complement. Altern. Med. 2020, 2, 202–236. [Google Scholar] [CrossRef]
- Mohiuddin, A.K.; Lia, S. Medicinal & Biological Investigations of Ficus racemosa. For. Agric. Rev. 2020, 1, 29–81. [Google Scholar] [CrossRef]
- More, R.V.; Chavan, S.S.; Shekade, P.P.; Dhabe, A.S. Production of Wine from Ficus racemosa L. Fruits and Phytochemical Screening through HRLC-MS Technique. J. Pharmacogn. Phytochem. 2024, 13, 171–173. [Google Scholar] [CrossRef]
- Pahari, N.; Majumdar, S.; Karati, D.; Mazumder, R. Exploring the Pharmacognostic Properties and Pharmacological Activities of Phytocompounds Present in Ficus racemosa Linn.: A Concise Review. Pharmacol. Res.—Mod. Chin. Med. 2022, 4, 100137. [Google Scholar] [CrossRef]
- Bokaeian, M.; Sheikh, M.; Hassanshahian, M.; Saeidi, S.; Sahraei, S. The Antibacterial Activity of Silver Nanoparticles Produced in the Plant Sesamum Indicum Seed Extract: A Green Method Against Multi-Drug Resistant Escherichia coli. Int. J. Enteric Pathog. 2014, 2, e17928. [Google Scholar] [CrossRef]
- Kotakadi, V.S.; Gaddam, S.A.; Venkata, S.K.; Sai Gopal, D.V.R. New Generation of Bactericidal Silver Nanoparticles against Different Antibiotic Resistant Escherichia coli Strains. Appl. Nanosci. 2015, 5, 847–855. [Google Scholar] [CrossRef]
- Momeni, M.; Asadi, S.; Samer; Shanbedi, M. Mehdi Antimicrobial Effect of Silver Nanoparticles Synthesized with Bougainvillea Glabra Extract on Staphylococcus aureus and Escherichia coli. Iran. J. Chem. Chem. Eng.-Int. Engl. Ed. 2021, 40, 395–405. [Google Scholar] [CrossRef]
- MubarakAli, D.; Thajuddin, N.; Jeganathan, K.; Gunasekaran, M. Plant Extract Mediated Synthesis of Silver and Gold Nanoparticles and Its Antibacterial Activity against Clinically Isolated Pathogens. Colloids Surf. B Biointerfaces 2011, 85, 360–365. [Google Scholar] [CrossRef] [PubMed]
- Kanagamani, K.; Muthukrishnan, P.; Ilayaraja, M.; Vinoth Kumar, J.; Shankar, K.; Kathiresan, A. Synthesis of Leucaena Mediated Silver Nanoparticles: Assessing Their Photocatalytic Degradation of Cr (VI) and in Vitro Cytotoxicity against DLA Cells. J. Photochem. Photobiol. A Chem. 2017, 346, 470–478. [Google Scholar] [CrossRef]
- Muthukrishnan, S.; Vellingiri, B.; Murugesan, G. Anticancer Effects of Silver Nanoparticles Encapsulated by Gloriosa superba (L.) Leaf Extracts in DLA Tumor Cells. Future J. Pharm. Sci. 2018, 4, 206–214. [Google Scholar] [CrossRef]
- Sujin Jeba Kumar, T.; Balavigneswaran, C.K.; Moses Packiaraj, R.; Veeraraj, A.; Prakash, S.; Natheer Hassan, Y.; Srinivasakumar, K.P. Green Synthesis of Silver Nanoparticles by Plumbago Indica and Its Antitumor Activity Against Dalton’s Lymphoma Ascites Model. BioNanoScience 2013, 3, 394–402. [Google Scholar] [CrossRef]
- Cvjetko, P.; Milošić, A.; Domijan, A.-M.; Vinković Vrček, I.; Tolić, S.; Peharec Štefanić, P.; Letofsky-Papst, I.; Tkalec, M.; Balen, B. Toxicity of Silver Ions and Differently Coated Silver Nanoparticles in Allium cepa Roots. Ecotoxicol. Environ. Saf. 2017, 137, 18–28. [Google Scholar] [CrossRef]
- Heikal, Y.M.; Şuţan, N.A.; Rizwan, M.; Elsayed, A. Green Synthesized Silver Nanoparticles Induced Cytogenotoxic and Genotoxic Changes in Allium cepa L. Varies with Nanoparticles Doses and Duration of Exposure. Chemosphere 2020, 243, 125430. [Google Scholar] [CrossRef]
- Kumari, M.; Mukherjee, A.; Chandrasekaran, N. Genotoxicity of Silver Nanoparticles in Allium cepa. Sci. Total Environ. 2009, 407, 5243–5246. [Google Scholar] [CrossRef] [PubMed]
- Abdelsalam, N.R.; Abdel-Megeed, A.; Ali, H.M.; Salem, M.Z.M.; Al-Hayali, M.F.A.; Elshikh, M.S. Genotoxicity Effects of Silver Nanoparticles on Wheat (Triticum aestivum L.) Root Tip Cells. Ecotoxicol. Environ. Saf. 2018, 155, 76–85. [Google Scholar] [CrossRef] [PubMed]
- Borovaya, M.; Naumenko, A.; Horiunova, I.; Plokhovska, S.; Blume, Y.; Yemets, A. “Green” Synthesis of Ag2S Nanoparticles, Study of Their Properties and Bioimaging Applications. Appl. Nanosci. 2020, 10, 4931–4940. [Google Scholar] [CrossRef]
- Ghosh, M.; Manivannan, J.; Sinha, S.; Chakraborty, A.; Mallick, S.K.; Bandyopadhyay, M.; Mukherjee, A. In Vitro and in Vivo Genotoxicity of Silver Nanoparticles. Mutat. Res./Genet. Toxicol. Environ. Mutagen. 2012, 749, 60–69. [Google Scholar] [CrossRef] [PubMed]
- Pesnya, D.S. Cytogenetic Effects of Chitosan-Capped Silver Nanoparticles in the Allium cepa Test. Caryologia 2013, 66, 275–281. [Google Scholar] [CrossRef]
- Pesnya, D.S.; Romanovsky, A.V. Comparison of Cytotoxic and Genotoxic Effects of Plutonium-239 Alpha Particles and Mobile Phone GSM 900 Radiation in the Allium cepa Test. Mutat. Res./Genet. Toxicol. Environ. Mutagen. 2013, 750, 27–33. [Google Scholar] [CrossRef]
- Yekeen, T.A.; Azeez, M.A.; Akinboro, A.; Lateef, A.; Asafa, T.B.; Oladipo, I.C.; Oladokun, S.O.; Ajibola, A.A. Safety Evaluation of Green Synthesized Cola Nitida Pod, Seed and Seed Shell Extract-Mediated Silver Nanoparticles (AgNPs) Using an Allium cepa Assay. J. Taibah Univ. Sci. 2017, 11, 895–909. [Google Scholar] [CrossRef]

| Treatment | Concentration (µL) | Mitotic Index (% ± SD) | Chromosomal Aberration (% ± SD) |
|---|---|---|---|
| Control (Distilled water) | 100 µL | 11.41 ± 0.21 | NIL |
| 200 µL | 12.69 ± 0.21 | NIL | |
| 300 µL | 13.14 ± 0.21 | NIL | |
| 400 µL | 14.79 ± 0.21 | NIL | |
| 500 µL | 15.24 ± 0.21 | NIL | |
| Experiment (Biosynthesized AgNPs) | 100 µL | 11 ± 0.03 | NIL |
| 200 µL | 12 ± 0.03 | 2 ± 0.03 | |
| 300 µL | 13.8 ± 0.03 | 3 ± 0.03 | |
| 400 µL | 14 ± 0.03 | 5 ± 0.03 | |
| 500 µL | 15 ± 0.03 | 6 ± 0.03 |
Disclaimer/Publisher’s Note: The statements, opinions and data contained in all publications are solely those of the individual author(s) and contributor(s) and not of MDPI and/or the editor(s). MDPI and/or the editor(s) disclaim responsibility for any injury to people or property resulting from any ideas, methods, instructions or products referred to in the content. |
© 2024 by the authors. Licensee MDPI, Basel, Switzerland. This article is an open access article distributed under the terms and conditions of the Creative Commons Attribution (CC BY) license (https://creativecommons.org/licenses/by/4.0/).
Share and Cite
Sabira, O.; Drisya, N.; Ajaykumar, A.P.; Mathew, A.; Narayanan Jayaraj, K.; Binitha, V.S.; Zeena, K.V.; Roy, K.B.; Janish, P.A.; Sheena, P.; et al. From Ficus recemosa Leaf Galls to Therapeutic Silver Nanoparticles: Antibacterial and Anticancer Applications. Pharmaceutics 2024, 16, 1025. https://doi.org/10.3390/pharmaceutics16081025
Sabira O, Drisya N, Ajaykumar AP, Mathew A, Narayanan Jayaraj K, Binitha VS, Zeena KV, Roy KB, Janish PA, Sheena P, et al. From Ficus recemosa Leaf Galls to Therapeutic Silver Nanoparticles: Antibacterial and Anticancer Applications. Pharmaceutics. 2024; 16(8):1025. https://doi.org/10.3390/pharmaceutics16081025
Chicago/Turabian StyleSabira, Ovungal, Nedumbayil Drisya, Anthyalam Parambil Ajaykumar, Asok Mathew, Kodangattil Narayanan Jayaraj, Valiyaparambil Sivadasan Binitha, Koladath Vasu Zeena, Kanakkassery Balan Roy, Pandikkadan Ayyappan Janish, Padannappurath Sheena, and et al. 2024. "From Ficus recemosa Leaf Galls to Therapeutic Silver Nanoparticles: Antibacterial and Anticancer Applications" Pharmaceutics 16, no. 8: 1025. https://doi.org/10.3390/pharmaceutics16081025
APA StyleSabira, O., Drisya, N., Ajaykumar, A. P., Mathew, A., Narayanan Jayaraj, K., Binitha, V. S., Zeena, K. V., Roy, K. B., Janish, P. A., Sheena, P., & Viswanathan, K. P. (2024). From Ficus recemosa Leaf Galls to Therapeutic Silver Nanoparticles: Antibacterial and Anticancer Applications. Pharmaceutics, 16(8), 1025. https://doi.org/10.3390/pharmaceutics16081025

